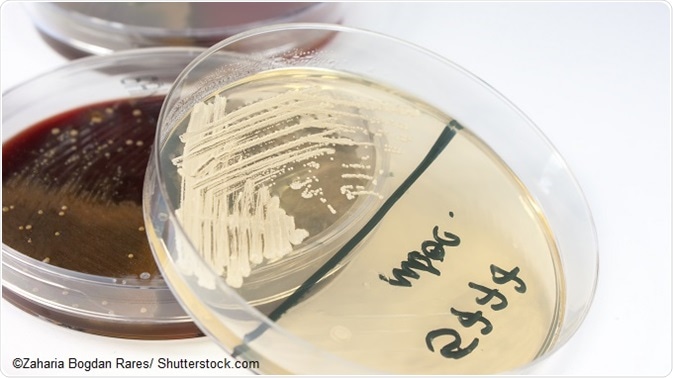

Oral thrush or oral candidiasis refers to infection of the mouth with the fungus Candida albicans. It is usually harmless, is not contagious and is easily treated with antifungal medication.
The Candida albicans fungus exists at low levels in the mouth and digestive system in most individuals, but in some cases, overgrowth can occur and lead to symptoms. If this happens, white lesions develop on the tongue and inside of the cheeks. In some cases, the lesions may also appear on the gums, tonsils, the roof of the mouth and the back of the throat.
Image: Candida albicans fungus on sabouraud agar.
Causes
In healthy individuals, the immune system works to fend off any bacteria, fungi and viruses that it recognises as invaders, while also ensuring that the right balance is kept between the “good” and “bad” microorganisms that already exist naturally in the body. However, weakened immunity can mean this system fails to keep Candida albicans levels in the mouth in check. If this happens, the fungus flourishes, which eventually leads to symptoms of infection. Factors that can upset the immune system’s protective mechanisms include certain health conditions, the use of certain medications and some lifestyle habits.
Health conditions
Some examples of health conditions that can increase susceptibility to this infection include:
- Diabetes: Diabetes that is left untreated or not adequately controlled can lead to a high sugar buildup up in the saliva. Saliva with a high sugar content provides a favorable environment for the growth of Candida albicans in the mouth.
- Yeast infection of the vagina: Candida albicans is the fungus that causes both oral thrush and vaginal thrush. Vaginal thrush is not a dangerous condition, but pregnant women with the condition can pass the fungus on to their babies during birth, which can mean the baby develops oral thrush.
- HIV/AIDS: Human immunodeficiency virus weakens the immune system by damaging and killing immune cells. The body is then less able to maintain a healthy balance of good and bad microbes, enabling Candida albicans to multiply in the mouth and cause symptoms.
Cancer: Both cancer itself and many of the procedures used to treat it, such as chemotherapy and radiotherapy, can weaken the immune system, again increasing the likelihood of Candida albicans infection taking hold in the mouth.
Medications
The use of the following medications can increase the risk of development of oral thrush:
- Antibiotics can disrupt the healthy balance of good and bad microbes in the body, particularly if taken over a long period or in high doses.
- The use of inhaled corticosteroids such as fluticasone or beclomethasone for asthma depresses the immune system in the lungs to help prevent the inflammation that causes the condition. On the way to the lungs, the drugs typically pass through the throat where they have the same effect and therefore disrupt the normal immune mechanisms that prevent Candida albicans from multiplying.
Lifestyle factors
Lifestyle factors that can upset the microbial balance in the mouth and lead to oral candidiasis include:
- Wearing dentures, especially if they do not fit properly or are not cleaned properly
- Poor oral hygiene
- Dry mouth
- Smoking
Symptoms
Symptoms of oral thrush may develop slowly or suddenly, depending on the underlying factor that may be causing the condition. They may persist for any period from a few days to a few months. Symptoms include:
- The formation of white lesions (plaques) that resemble cottage cheese, and occur on the tongue, on the inside of the cheeks, on the roof of the mouth, on the tonsils and in the back of the throat. If the lesions are wiped or scraped away, they may leave raw red areas with slight bleeding.
- Soreness, redness, pain and burning in the mouth and back of the throat that may cause difficulty with eating and swallowing.
- Cracks and redness at the corners of the mouth.
- Loss of taste.
When to see the doctor
Symptoms of oral thrush are an indication for the need to be examined by a doctor, since the condition will continue to cause discomfort unless it is treated. In some uncommon cases, untreated oral thrush can become severe and infection can spread to other parts of the body and cause serious problems. A doctor can usually diagnose the problem simply by looking at the mouth, although sometimes blood tests may be performed to check for underlying health conditions associated with oral thrush, such as diabetes.
References
- http://www.mayoclinic.org/diseases-conditions/oral-thrush/basics/definition/con-20022381
- http://www.nhs.uk/Conditions/Oral-thrush---adults/Pages/Introduction.aspx
Further Reading
Last Updated: Feb 27, 2019